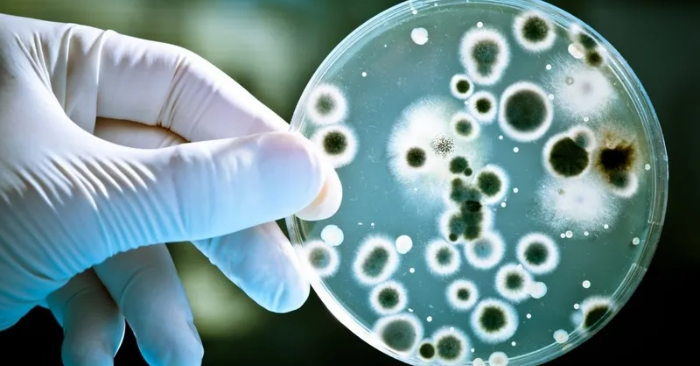

Phòng ngừa dịch tả xâm nhập, Bộ Y tế đưa ra khuyến cáo khẩn
Bộ Y tế cảnh báo nguy cơ dịch tả xâm nhập Việt Nam, đề nghị người dân tăng cường phòng bệnh, tuân thủ vệ sinh và chủ động theo dõi sức khỏe.
- Tài xế đập kính, hành hung đồng nghiệp giữa ngã tư TP.HCM
- Vụ cướp tiệm tạp hóa gây sốc
- Cây dong riềng đỏ – “thần dược” hỗ trợ phòng ngừa đột quỵ và nhồi máu cơ tim
Nguy cơ dịch tả xâm nhập do giao lưu thương mại và du lịch
Theo Tổ chức Y tế thế giới (WHO), từ đầu năm 2025 đến ngày 29/8, toàn cầu ghi nhận hơn 409.000 ca mắc tả, trong đó có 4.738 trường hợp tử vong tại 31 quốc gia. Dù số ca mắc giảm 20% so với cùng kỳ năm trước, số tử vong lại tăng tới 46%, cho thấy dịch đang diễn biến phức tạp và khó lường.
WHO đánh giá nguy cơ lây lan giữa các quốc gia là rất cao; đặc biệt ở khu vực Đông Địa Trung Hải và châu Phi. Hiện nay, Việt Nam đã 12 năm chưa ghi nhận ca mắc bệnh tả, nhưng với hoạt động thương mại, du lịch quốc tế ngày càng rộng mở; khả năng dịch xâm nhập và lây lan cộng đồng không thể loại trừ.
Ngay khi WHO phát đi cảnh báo, Bộ Y tế đã chủ động cập nhật thông tin, đồng thời chỉ đạo các đơn vị y tế tăng cường giám sát, phát hiện sớm ca nghi ngờ tại cửa khẩu, cộng đồng và cơ sở y tế.
Khuyến cáo phòng chống dịch tả từ Bộ Y tế
Bệnh tả là bệnh truyền nhiễm nguy hiểm, do vi khuẩn Vibrio cholerae gây ra, lây qua đường tiêu hóa. Người bệnh thường có triệu chứng tiêu chảy cấp, mất nước, rối loạn điện giải, có thể dẫn đến tử vong nếu không điều trị kịp thời.
Để phòng ngừa dịch tả, Bộ Y tế khuyến cáo người dân:
- Rửa tay thường xuyên bằng xà phòng trước khi ăn, sau khi đi vệ sinh và khi chế biến thực phẩm.
- Ăn chín, uống sôi; sử dụng nguồn nước sạch và bảo vệ nguồn nước sinh hoạt.
- Thu gom rác thải, giữ gìn vệ sinh môi trường, diệt ruồi nhặng.
- Người trở về từ vùng có dịch cần theo dõi sức khỏe trong vòng 5 ngày; nếu có triệu chứng bất thường như nôn, tiêu chảy nhiều, mất nước nghiêm trọng… phải đến ngay cơ sở y tế, không tự ý điều trị tại nhà.
- Khi đi công tác hoặc du lịch tại vùng có dịch; cần chủ động phòng bệnh và thông báo cơ quan y tế khi có dấu hiệu nghi ngờ.
Bộ Y tế nhấn mạnh: việc chủ động phòng ngừa; giám sát chặt chẽ và nâng cao ý thức cộng đồng là yếu tố quyết định để ngăn chặn nguy cơ dịch tả xâm nhập và bùng phát tại Việt Nam.
Theo: Nhandan
